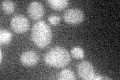
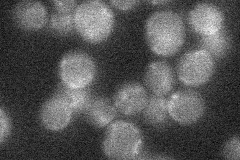

View description
Permease of basic amino acids in the vacuolar membrane
Localization:
Intensity:
Fold change:
Significance:
-
C’ GFP library in SD
below threshold14.51 -
N' NOP1pr-GFP in SD

ER33.0214 -
N' TEF2pr-mCherry in SD

ER27.7172 -
N' NATIVEpr-GFP in SD
below threshold18.3533 -
N' TEF2pr-VC and Cyto-VN in SD

below threshold25.1524 -
C’ GFP library in SD+DTT

cytosol14.71.01No -
C’ GFP library in SD+H2O2

cytosol16.341.12No -
C’ GFP library in Starvation Media

cytosol15.921.09No -
C’ GFP library on the background of Pup2-DaMP

below threshold -
C’ GFP library on the background of CCT mutant

below threshold17.22771.187No
